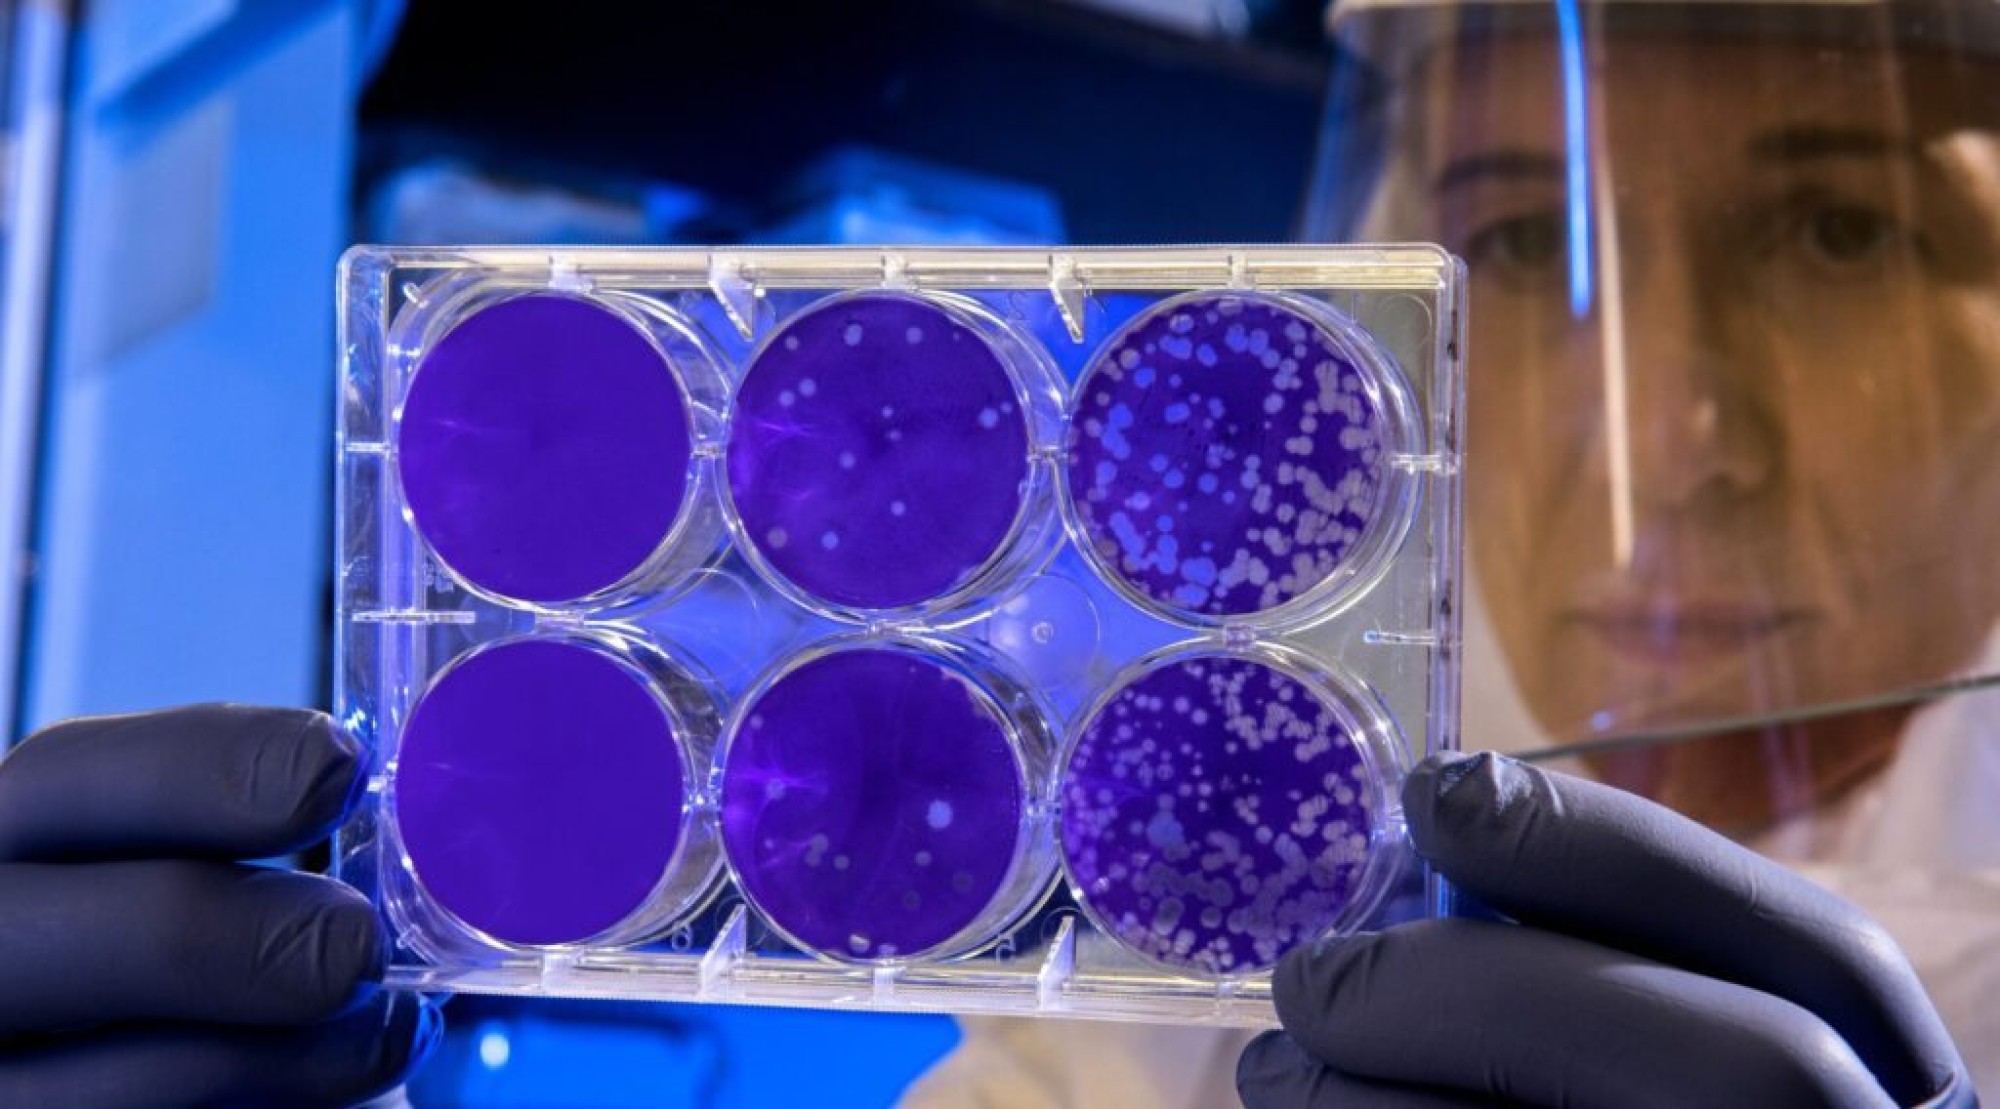

02.01.24 | Inovação
Startup israelense desenvolve terapia inovadora contra câncer em estágio avançado
O site Israel de Fato, com o qual a CONIB tem parceria, noticiou que a startup israelense New Phase desenvolveu uma abordagem inovadora para enfrentar o câncer em estágio quatro, transformando a condição em doença crônica. A técnica consiste em utilizar nanopartículas revestidas de glicose para aquecer tumores sólidos a cerca de 50 graus Celsius, resultando na eliminação das células cancerosas.
O Sistema Nanotecnológico Sarah, da New Phase, administra as nanopartículas por meio de injeção intravenosa, permitindo que elas alcancem os tumores através de vasos sanguíneos finos. Após um bem-sucedido ensaio clínico em Israel, o sistema recebeu aprovação da FDA nos EUA. O objetivo não é a erradicação total do câncer, mas sim transformá-lo em uma condição crônica, prolongando a vida dos pacientes.
O tratamento já demonstrou sucesso em pacientes, permitindo que alguns se tornem elegíveis para outras terapias após a redução significativa do câncer. Financiada privadamente, a New Phase busca aprovação para a próxima fase do tratamento em Israel. Este avanço representa uma abordagem inovadora na luta contra o câncer, proporcionando esperança e uma nova perspectiva para os que têm a doença.